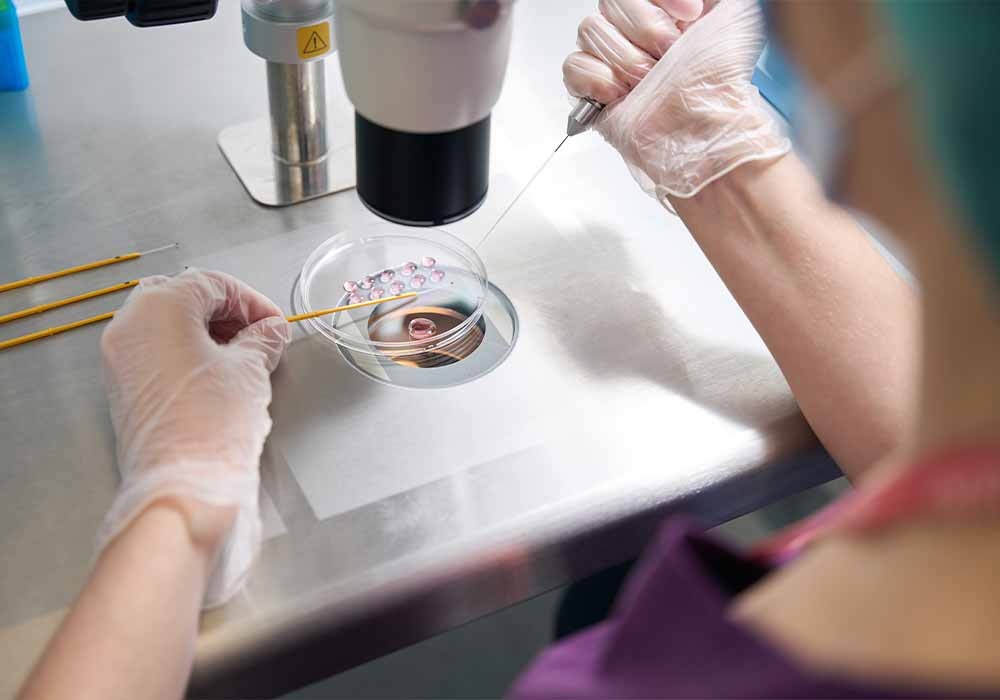
fivet-napoli-vomero

Dopo un lungo percorso di fecondazione assistita, la gioia di vedere un test positivo è immensa. Ma subito dopo l’emozione, arriva una domanda che si pongono quasi tutte le pazienti: di quante settimane sono incinta?
Non si tratta solo di soddisfare una curiosità. Sapere con precisione l’età gestazionale è fondamentale per seguire lo sviluppo dell’embrione, programmare le ecografie e gestire con attenzione ogni fase della gravidanza.
Nelle gravidanze naturali, il conteggio delle settimane si basa sul primo giorno dell’ultima mestruazione, un metodo universalmente utilizzato che però ha un certo margine di errore. Questo perché il giorno esatto dell’ovulazione e della fecondazione non sempre è noto e può variare sensibilmente anche in cicli regolari. Per questo, nel calcolo tradizionale, si assume che il concepimento avvenga intorno al 14° giorno del ciclo e si stimano 280 giorni (cioè 40 settimane) fino al parto.
Nel caso della FIVET, invece, il vantaggio è evidente: si parte da dati certi. Conosciamo esattamente il giorno in cui è avvenuta la fecondazione e quello del trasferimento in utero dell’embrione. Questo permette di stabilire con maggiore precisione quando è iniziata la gravidanza e di calcolare in modo più accurato la data presunta del parto.
A seconda dell’età dell’embrione al momento del transfer – che può essere di 3 giorni, di 5 (blastocisti), o anche congelato – si fa risalire l’inizio della gravidanza proprio a quel numero di giorni prima del transfer. A partire da quel momento, si sommano 266 giorni, ovvero 38 settimane, per avere una stima realistica del termine della gravidanza. Questo perché nel calcolo FIVET non si includono i 14 giorni “virtuali” del metodo ostetrico, dato che la data del concepimento è effettivamente nota.
Nei controlli ginecologici si adotta comunque la terminologia ostetrica per uniformità. Per questo, si può effettuare una conversione: basta aggiungere i giorni mancanti per arrivare ai 14 “standard” previsti dal conteggio basato sull’ultima mestruazione. Ad esempio, con una blastocisti di 5 giorni, si aggiungono 9 giorni al giorno del transfer per ottenere l’equivalente ostetrico.
Questo passaggio può sembrare complesso, ma in realtà consente di avere un quadro estremamente preciso, utile per valutare la crescita embrio-fetale e monitorare eventuali situazioni a rischio, soprattutto nei primi mesi. Va anche ricordato che, come in tutte le gravidanze, la data presunta del parto rimane comunque una stima: solo una piccola percentuale di nascite avviene esattamente in quella giornata.
In ogni caso, affrontare una gravidanza dopo FIVET richiede attenzione, continuità di cura e una guida competente. Un ginecologo esperto in fertilità può accompagnare con delicatezza e rigore ogni paziente in questo percorso prezioso e unico.
Il Dott. Massimiliano Pellicano riceve presso il Centro Delta, in
Via Alessandro Scarlatti, 88 – 80129 Napoli (7° piano)
Per prenotazioni: +39 0815784014
Per informazioni: +39 0813795759
Per approfondire consulta il sito www.massimilianopellicano.it






